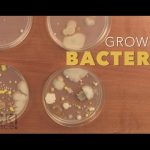
Growing Bacteria – Sick Science! #210

See the full experiment here: http://www.stevespanglerscience.com/lab/experiments/growing-bacteria
Get everything you need here: http://www.stevespanglerscience.com/bacteria-growing-kit.html
This activity will prove that Mom was right… “Wash your hands with soap and warm water!” A Petri dish prepared with nutrient agar (a seaweed derivative with beef nutrients) is an ideal food source for the bacteria you’ll be growing. In this experiment, Steve Spangler collected samples from items around the office – you will not believe what he found.
Want more experiments like this? Check out http://www.stevespanglerscience.com/product/naked-eggs-and-flying-potatoes
Sick Science™ is a trademark of Steve Spangler, inc.
© 2014 Steve Spangler Science all rights reserved